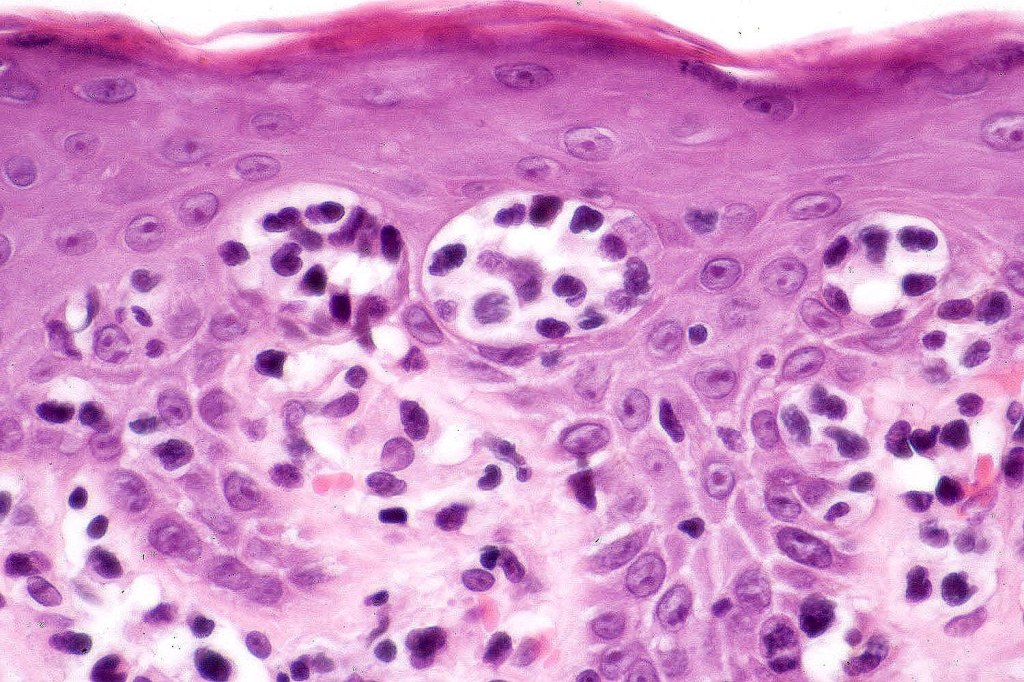
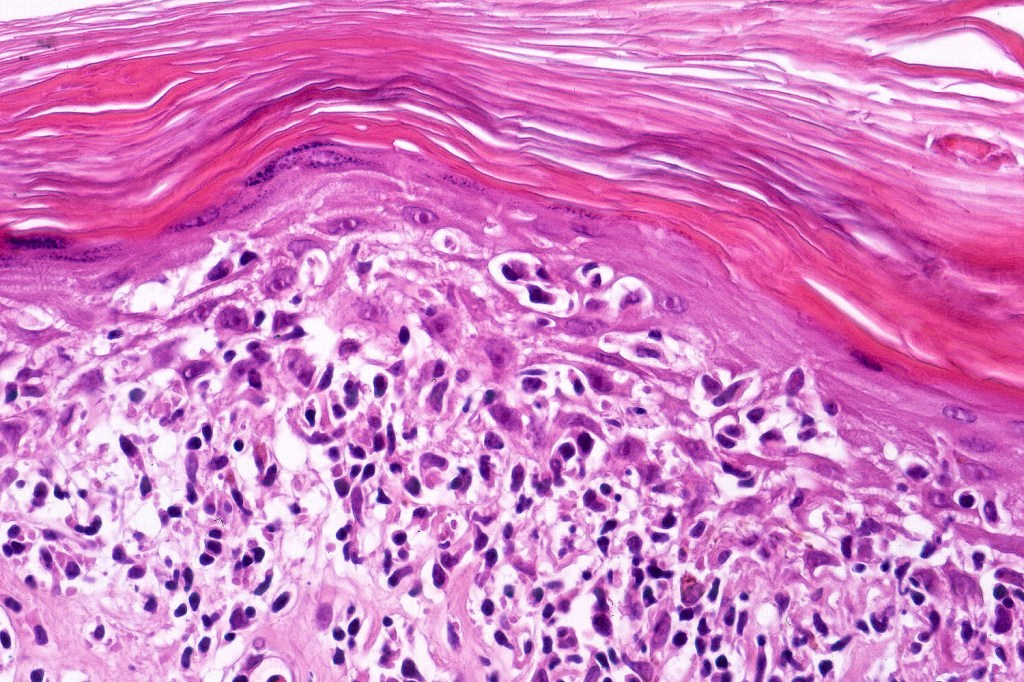
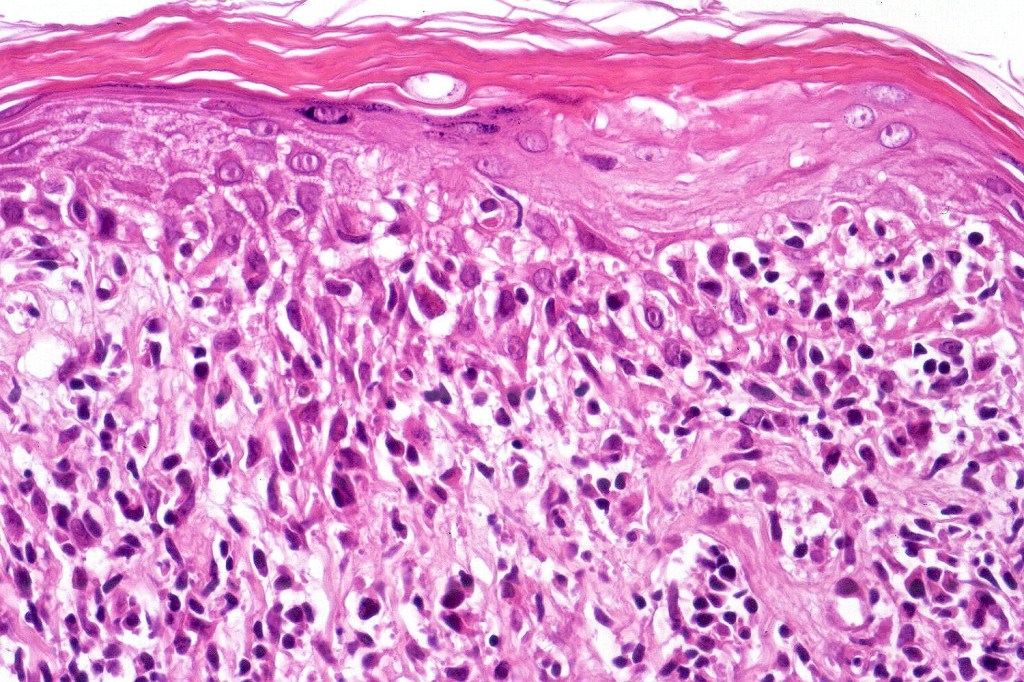
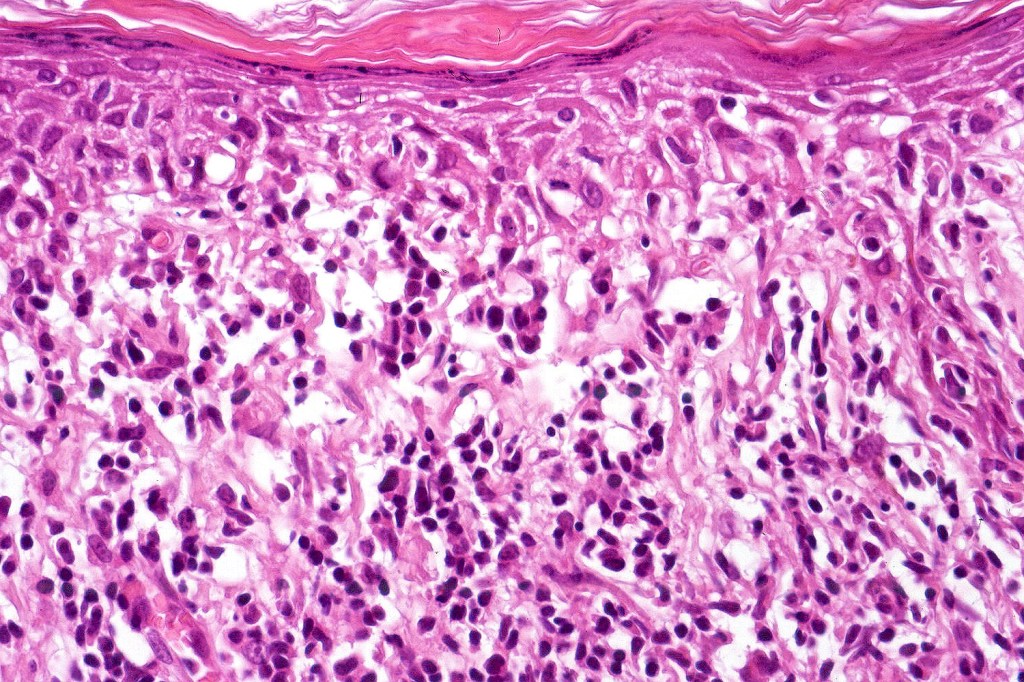
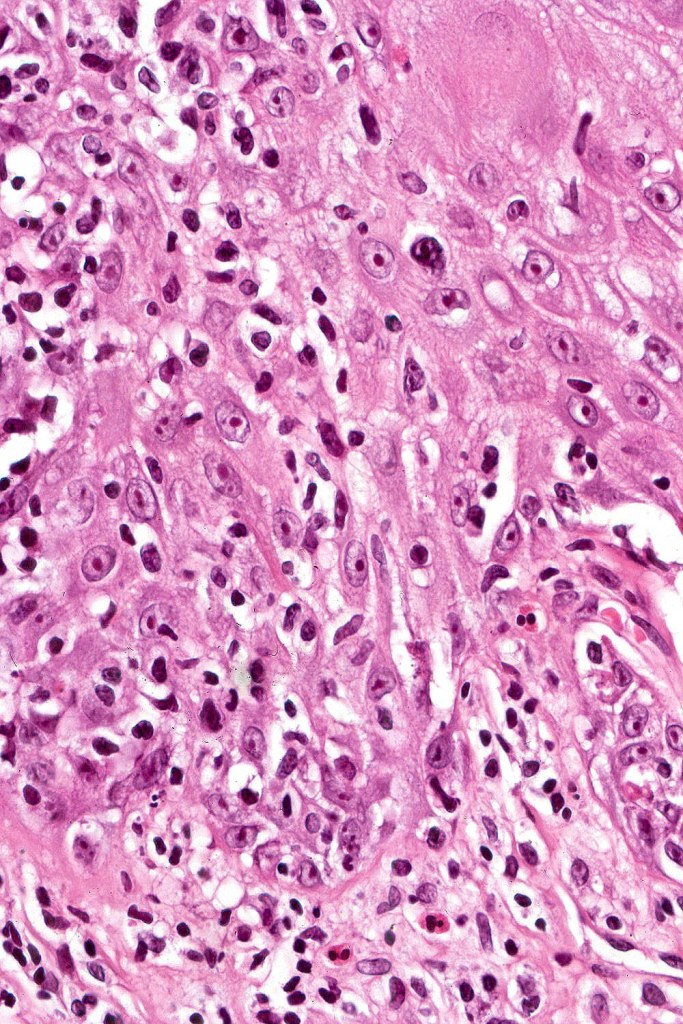
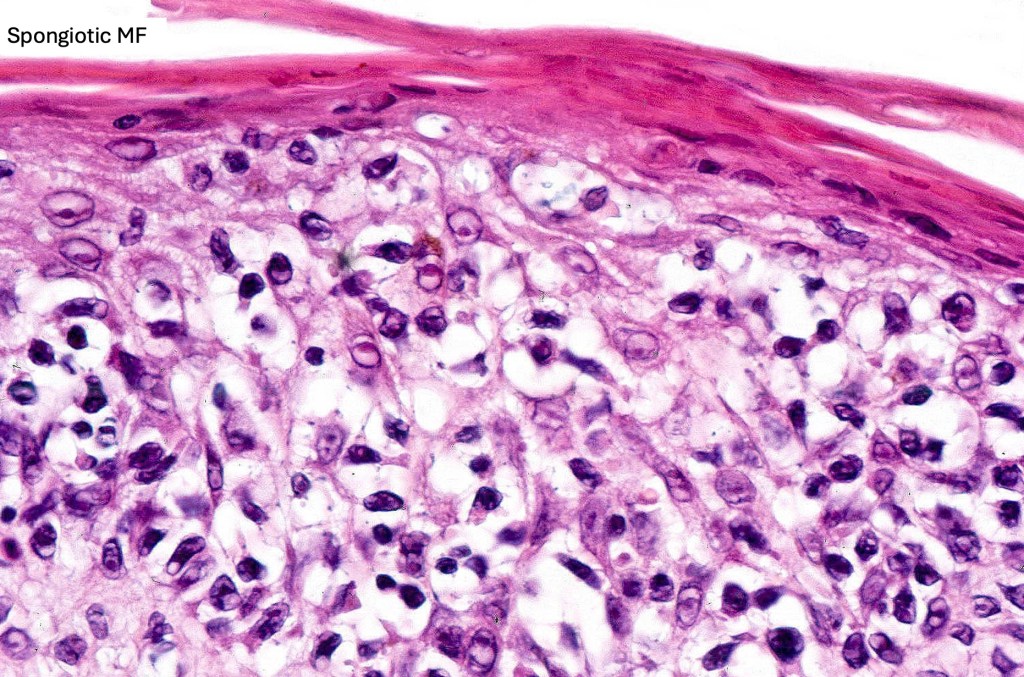
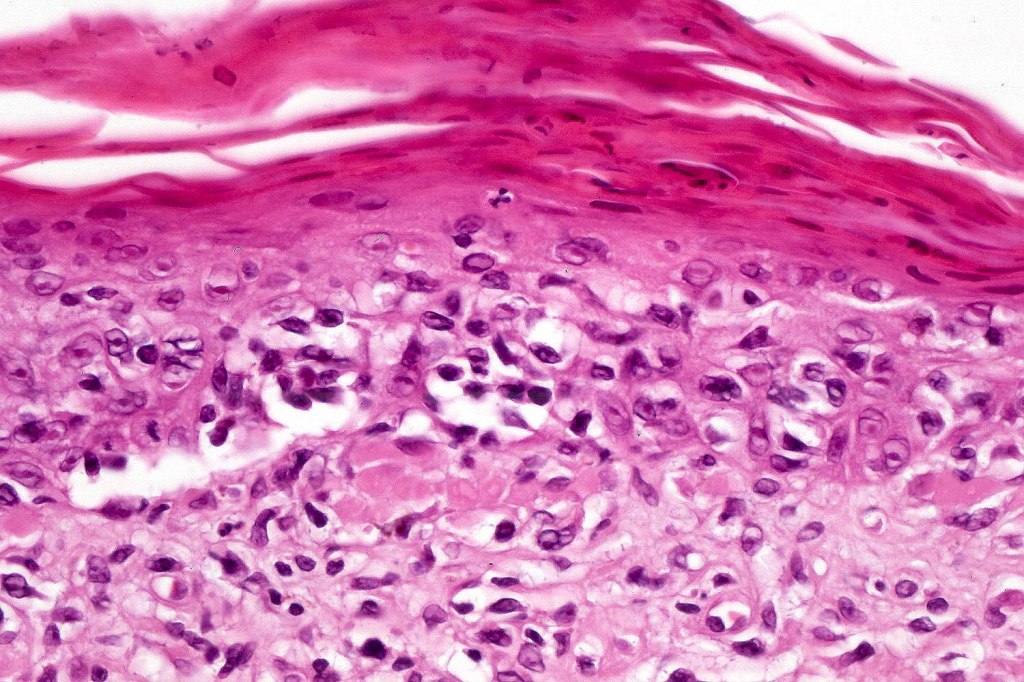
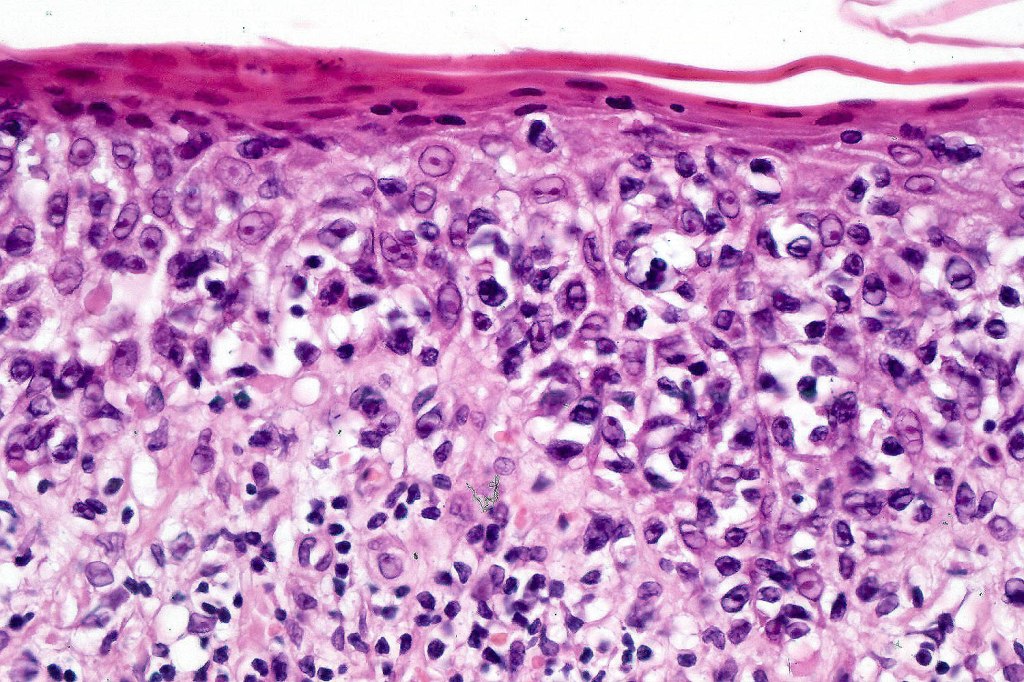
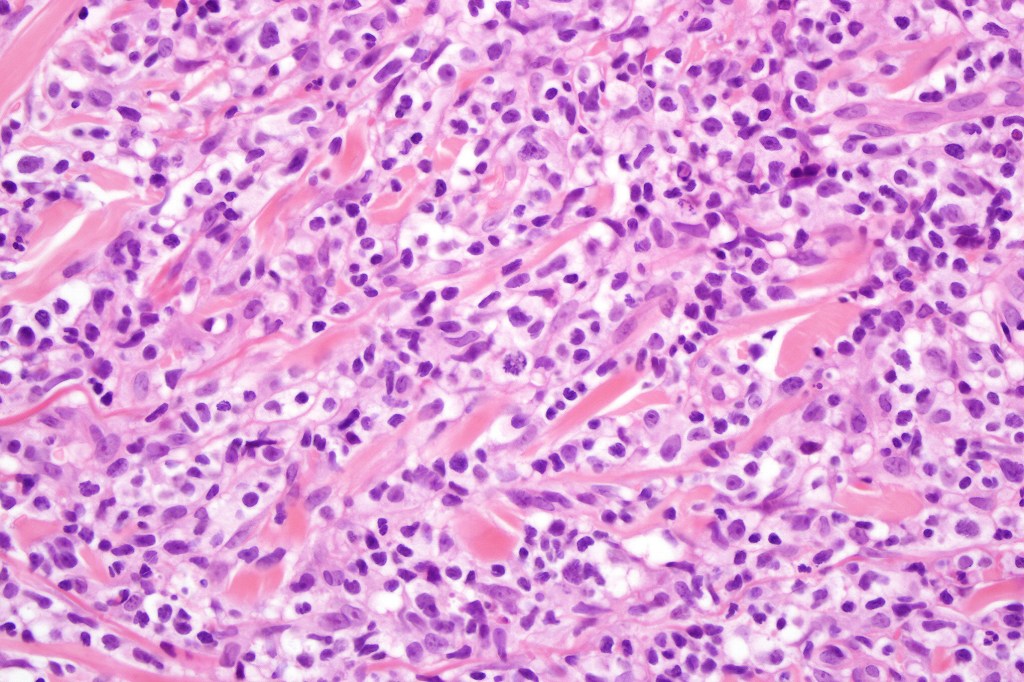
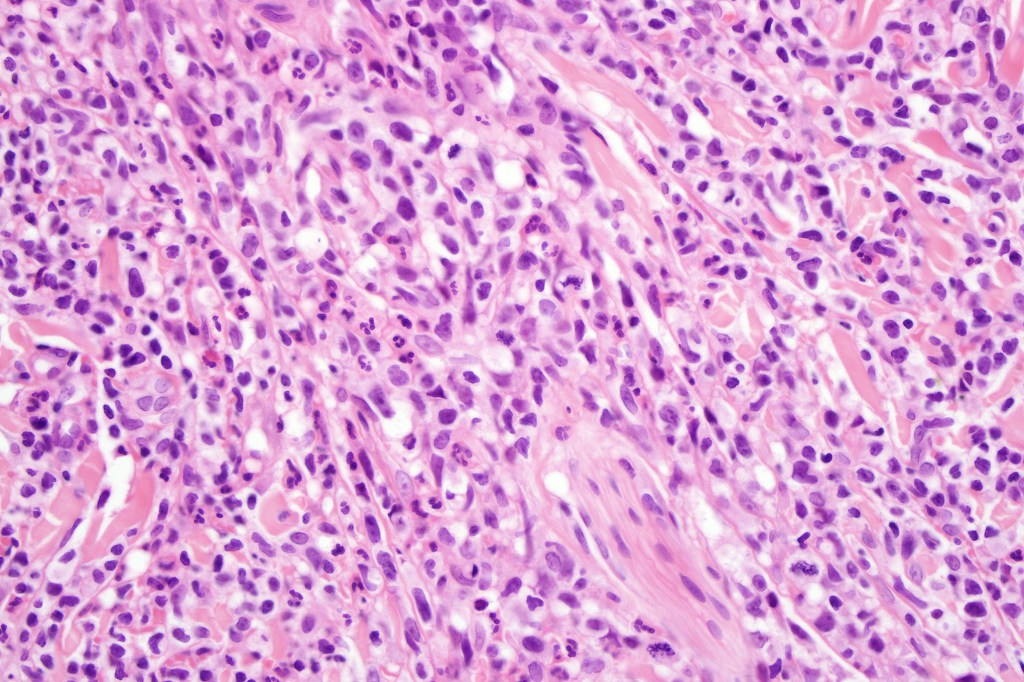
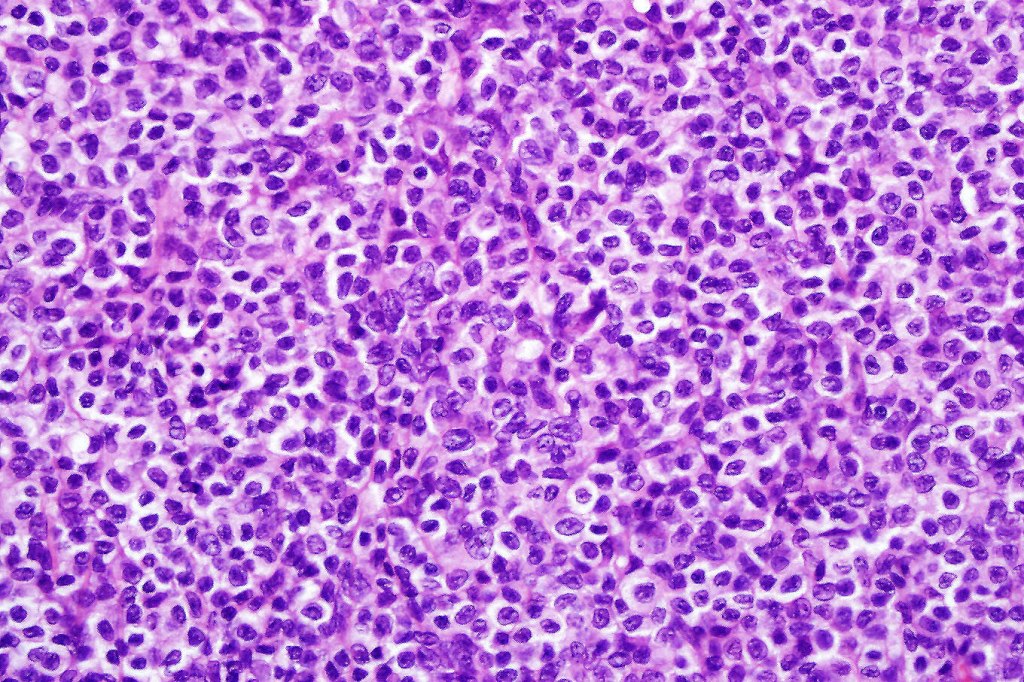
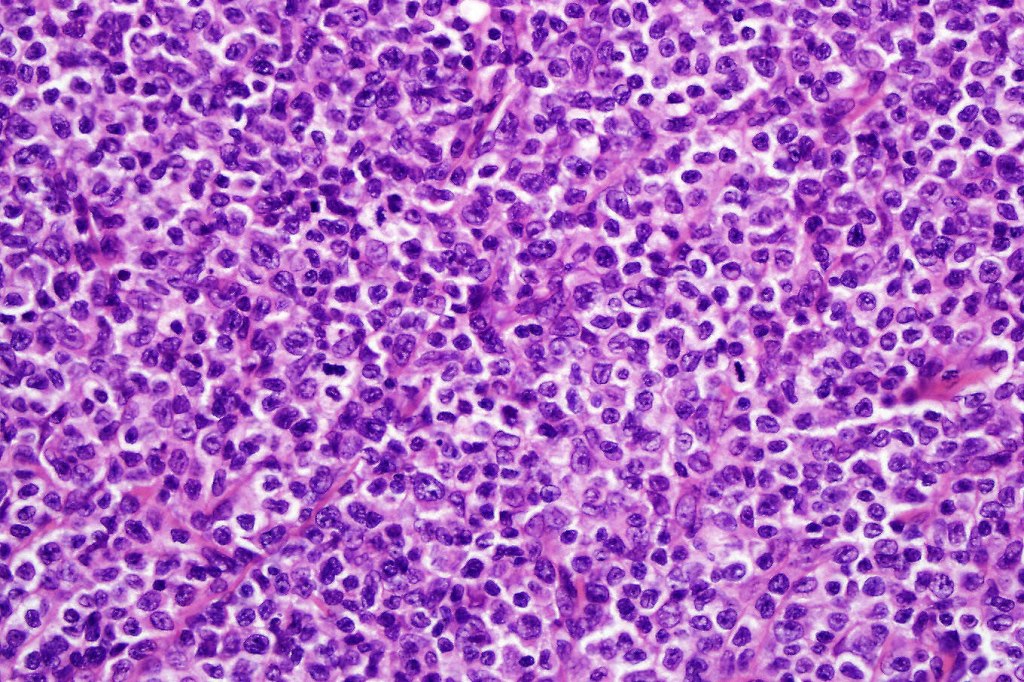
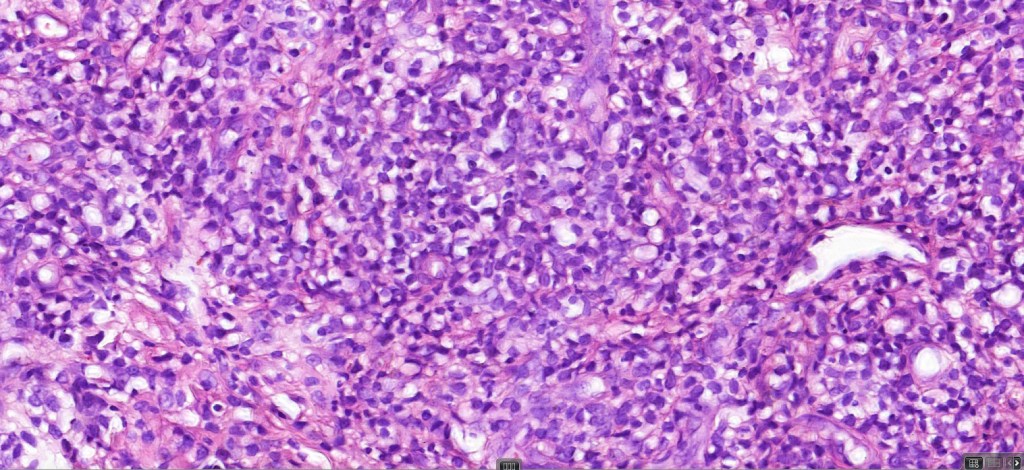

This is such a large topic. The blog focuses on the clinical appearances and histology.
Clinical features
•Commonest form of cutaneous T-cell lymphoma although it is very rare with around 1000 new cases diagnosed annually in the USA
•2M:1 F
•Most common in 4th-6th decades, childhood disease is discussed in a separate blog
•In most patients, the disease is relatively benign, but a small percentage progress to tumors stage disease with high mortality
•By tradition, divided into patch, plaque & tumor stage disease although patches & plaques often merge
•Patch stage disease is characterized by erythematous, scaly lesions with a predilection for the trunk, limb girdles, breasts & flexures; variably sized and shaped
•Plaque stage disease is characterized by scaly, erythematous scaly plaques sometimes with an annular or serpiginous morphology
•Tumor stage disease shows a predilection for the face, scalp & intertriginous regions
•Important variants of mycosis fungoides include poikiloderma atrophicans vasculare (poikiodermatous mycosis fungoides, large plaque parapsoriasis), erythrodermatous mycosis fungoides (not to be confused with Sézary syndrome), syringotropic & folliculotropic mycosis fungoides, Pagetoid reticulosis & granulomatous slack skin, mycosis fungoides in children & adolescents (these are all described in separate blogs)
•Rare clinical variants include bullous, hypopigmented, pustular, papular, granulomatous, palmoplantar psoriasiform , acanthosis nigricans-like mycosis, hypopigmented, hyperpigmented, vesiculobullous, pustular, pigmented purpura-like, unilesional, verrucous & invisible (severe pruritus with no visible skin lesions). One patient that I encountered could regularly predict devlopment of a new lesion long before it was clinically apparent just on the basis of a “new itch”.
Staging mycosis fungoides (American Cancer Society)
T categories
T1: Skin lesions can be small patches (flat lesions), papules (small bumps), and/or plaques (raised or lowered, flat lesions), but the lesions cover less than 10% of the skin surface.
T2: The patches, papules, and/or plaques cover 10% or more of the skin surface.
T3: At least one of the skin lesions is a tumor (a lesion growing deeper into the skin) that is at least 1 centimeter (cm) (a little less than 1/2 inch) across.
T4: The skin lesions have grown together to cover at least 80% of the skin surface.
N categories
N0: Lymph nodes are not enlarged and a lymph node biopsy is not needed.
N1: Lymph nodes are enlarged, but the patterns of cells look normal or close to normal under the microscope.
N2: Lymph nodes are enlarged, and the patterns of cells look more abnormal under the microscope.
N3: Lymph nodes are enlarged, and the patterns of cells look very abnormal under the microscope.
NX: Lymph nodes are enlarged but haven’t been removed (biopsied) to be looked at under the microscope.
M categories
M0: The lymphoma cells have not spread to other organs.
M1: Lymphoma cells have spread to other organs, such as the liver or spleen.
B categories
B0: No more than 5% of lymphocytes in the blood are Sezary (lymphoma) cells.
B1: Low numbers of Sezary cells in the blood (more than in B0 but less than in B2).
B2: High number of Sezary cells in the blood.
Stage grouping
Once the values for T, N, M, and B are known, they are combined to determine the overall stage of the lymphoma. This process is called stage grouping.
Mycosis fungoides (MF) and Sezary syndrome (SS) stages range from I (1) through IV (4). As a rule, the lower the number, the less the cancer has spread. A higher number, such as stage IV, means cancer has spread more. And within a stage, an earlier letter means a lower stage. Although each person’s cancer experience is unique, cancers with similar stages tend to have a similar outlook and are often treated in much the same way.
Stage IA: T1, N0, M0, B0 or B1
There are skin lesions but no tumors. Skin lesions cover less than 10% of the skin surface (T1), the lymph nodes are not enlarged (N0), lymphoma cells have not spread to other organs (M0), and the number of Sezary cells in the blood is not high (B0 or B1).
Stage IB: T2, N0, M0, B0 or B1
There are skin lesions but no tumors. Skin lesions cover at least 10% of the skin surface (T2), the lymph nodes are not enlarged (N0), lymphoma cells have not spread to other organs (M0), and the number of Sezary cells in the blood is not high (B0 or B1).
Stage IIA: T1 or T2, N1 or N2, M0, B0 or B1
There are skin lesions but no tumors. Skin lesions can cover up to 80% of the skin surface (T1 or T2). Lymph nodes are enlarged but the patterns of cells do not look very abnormal under the microscope (N1 or N2). Lymphoma cells have not spread to other organs (M0), and the number of Sezary cells in the blood is not high (B0 or B1).
Stage IIB: T3, N0 to N2, M0, B0 or B1
At least one of the skin lesions is a tumor that is 1 cm across or larger (T3). The lymph nodes are either normal (N0) or are enlarged but the patterns of cells do not look very abnormal under the microscope (N1 or N2). Lymphoma cells have not spread to other organs (M0), and the number of Sezary cells in the blood is not high (B0 or B1).
Stage IIIA: T4, N0 to N2, M0, B0
Skin lesions cover at least 80% of the skin surface (T4). The lymph nodes are either normal (N0) or are enlarged but the patterns of cells do not look very abnormal under the microscope (N1 or N2). Lymphoma cells have not spread to other organs or tissues (M0), and no more than 5% of the lymphocytes in the blood are Sezary cells (B0).
Stage IIIB: T4, N0 to N2, M0, B1
Skin lesions cover at least 80% of the skin surface (T4). The lymph nodes are either normal (N0) or are enlarged but the patterns of cells do not look very abnormal under the microscope (N1 or N2). Lymphoma cells have not spread to other organs (M0), and the number of Sezary cells in the blood is low (B1).
Stage IVA1: Any T, N0 to N2, M0, B2
Skin lesions can cover any amount of the skin surface (any T). The lymph nodes are either normal (N0) or are enlarged but the patterns of cells do not look very abnormal under the microscope (N1 or N2). Lymphoma cells have not spread to other organs (M0), and the number of Sezary cells in the blood is high (B2).
Stage IVA2: Any T, N3, M0, any B
Skin lesions can cover any amount of the skin surface (any T). Some lymph nodes are enlarged and the patterns of cells look very abnormal under the microscope (N3). Lymphoma cells have not spread to other organs (M0). Sezary cells may or may not be in the blood (any B).
Stage IVB: Any T, any N, M1, any B
Skin lesions can cover any amount of the skin surface (any T). The lymph nodes may be normal or abnormal (any N), and Sezary cells may or may not be in the blood (any B). Lymphoma cells have spread to other organs, such as the liver or spleen (M1).












Histological features
The histological hallmark of mycosis fungoides is the presence of large atypical lymphocytes with a convoluted/cerebriform nuclear border (Sézary cells). These may be found at the epidermal-dermal jnuction and as collections within the epidermis (Pautrier microabscess). These are most easily found in plaque stage disease. The epidermal component can be subtle in patch stage disease and is often lost in tumor stage dsease. The classification into patch, plaque & tumor stage disease is less helpful histologically as the features merge from one to the other. It is all a matter of degree.

Patch stage disease
•Changes can be subtle & dependent on clinicopathological correlation; in many patients sequential biopsies over many months may be necessary to establish the diagnosis.
•Mild hyperkeratosis & focal parakeratosis, acanthosis, epidermal atrophy or of normal thickness
•Superficial dermal lymphocytic infiltrate containing variable numbers of Sézary cells with atypical, irregular, hyperchromatic nuclei surrounded by a halo; these can be very few in number and dependant on viewing multiple levels
•Palisading of atypical lymphocytes along the epidermal-dermal border
•Pautrier microabscesses may be present but are often absent in patch stage disease
•Variable interface change with keratinocyte necrosis & pigmentary incontinence
•Eosinophils & plasma cells sometimes present
•Coarse collagen bundles in the papillary dermis can be a feature but this is not as marked as seen in plaque disease
.Although in typical mycosis fungoides fungoides, spongiosis is absent, exceptionally it can be a feature



















Plaque Stage Disease
•Compact hyperkeratosis & patchy parakeratosis
•Acanthosis
•Psoriasiform hyperplasia common
•Epidermotropism is often marked with conspicuous Pautrier microabscesses
•Lichenoid variant & poikiloderma atrophicans vasculare
•Variable folliculotropism (+/- mucinosis) & syringotropism
•Coarse collagen bundles in papillary dermis
•Superficial band-like dermal infiltrate of atypical lymphocytes, eosinophils, plasma cells & histiocytes

Tumor Stage Disease
•Epidermotropism is often minimal or absent
•Dense, broad diffuse or nodular, dermal infiltrate often extending into the subcutaneous fat
•Abundant Sézary cells. Frequently accompanied by very pleomorphic forms
•Mitoses often abundant, frequently abnormal
•CD30 expression correlates with transformation (cells X4 size of small lymphocytes comprising 25% or more of the infiltrate or the presence of a distinct large nodule)

Immunohistochemistry
•Clonal T-cell receptor rearrangement is supportive but not diagnosis of mycosis fungoides as it may be seen in a variety of inflammatory dermatoses
•TCRβ, CD45RO, IL-2R, CLA, CD25, CD2, CD3, CD4, CD5, CD7 +ve
•Much less often CD8+ve
•Variable loss of CD5 (supports the diagnosis) & CD7 (not so helpful as also seen in inflammatory dermatoses)
.TCRγ, TIA, granzyme & EBER -ve











Differential diagnosis
Patch stage disease must be distinguished from superficial scaly dermatitis (digitate dermatosis). The latter presents with multiple fairly uniform, erythematous (cigarette paper) lesions predominatly affecting the trunk & limbs. A digitate pattern is characteristic. Histologically, spongiotic dermatitis is seen in the absence of atypical lymphocytes & Sézary cells.
Lymphomatoid drug reaction can sometimes show histological features very similar to patch stage disease. Distinction is very much dependant on clinicopathological correlation.
Leave a comment